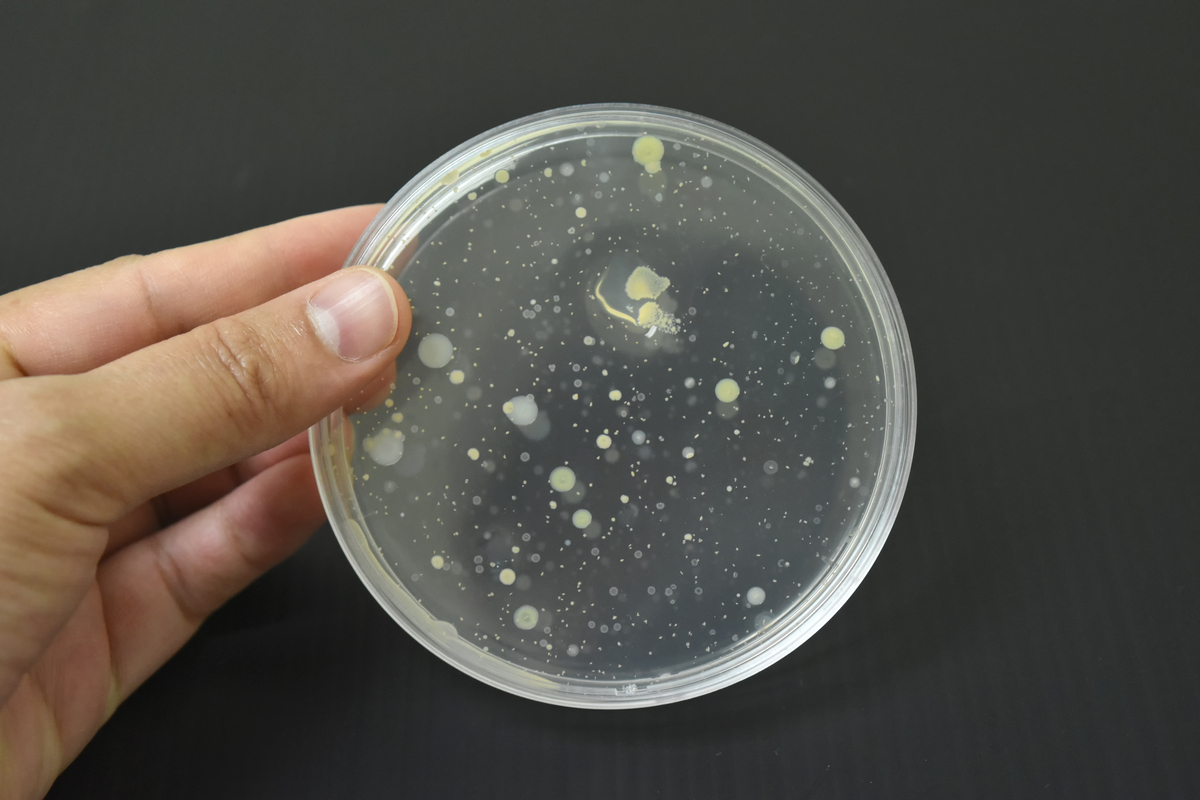
保证原文意思不变请用其他的中文表述重新表达下面这句话。念珠菌是广泛存在于自然界的条件致病真菌临床上以白念珠菌最为常见其存在酵母态、假菌丝态和菌丝态3种形态

保证原文意思不变请用其他的中文表述重新表达下面这句话。念珠菌是广泛存在于自然界的条件致病真菌临床上以白念珠菌最为常见其存在酵母态、假菌丝态和菌丝态3种形态
念珠菌是一种常见的具有致病性的真菌,广泛分布于自然界。在临床上,白念珠菌是最常见的种类,它可以以酵母态、假菌丝态和菌丝态三种形态存在。

原文地址: https://www.cveoy.top/t/topic/hfLk 著作权归作者所有。请勿转载和采集!
安全问答是一个知识全球问答,包含丰富的问答知识
念珠菌是一种常见的具有致病性的真菌,广泛分布于自然界。在临床上,白念珠菌是最常见的种类,它可以以酵母态、假菌丝态和菌丝态三种形态存在。
原文地址: https://www.cveoy.top/t/topic/hfLk 著作权归作者所有。请勿转载和采集!